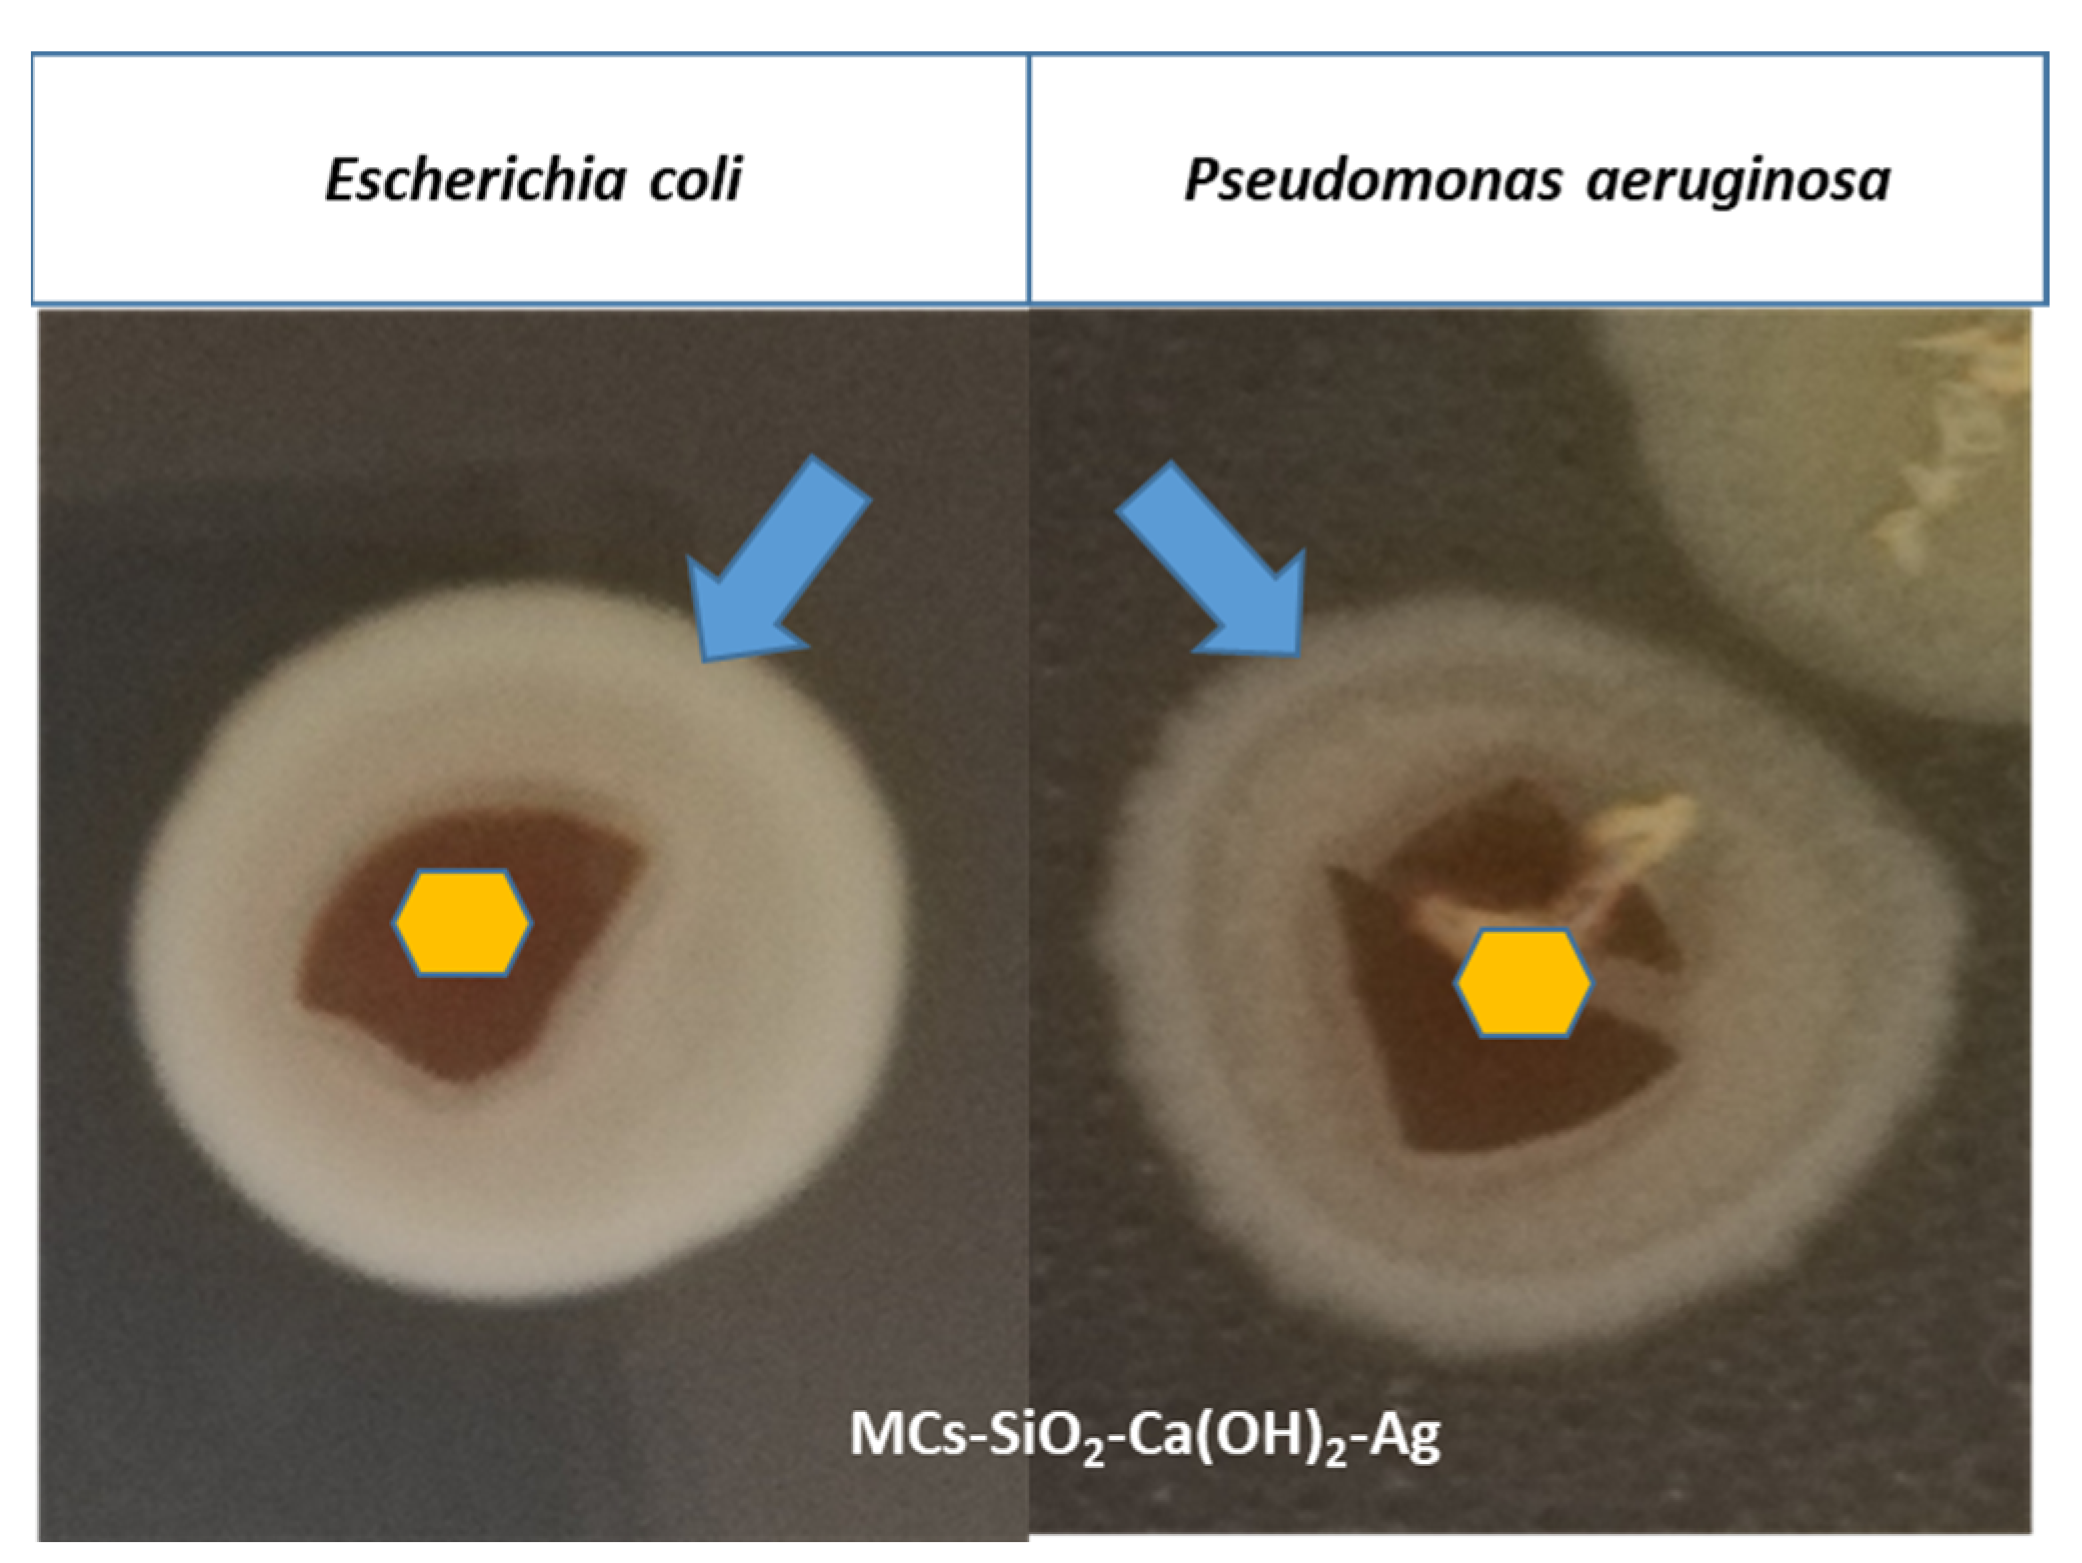
Crystals 15 00615 g009

3. Results and Discussion
A novel functionalized magnetic nanomaterial was developed, consisting of hydrophilic magnetic clusters coated with a double layer of silica, SiO
2, and calcium hydroxide, Ca(OH)
2, and decorated with silver nanoparticles for enhanced antimicrobial properties. The synthesis protocol integrates several methods, previously applied individually, into a simplified and integrated process designed to ensure the required structural, chemical, and functional properties of the final material. The protocol is presented schematically in
Figure 1 and includes the following four consecutive steps:
Step 1: Formation of hydrophilic magnetic clusters via direct oil-in-water miniemulsion;
Step 2: Coating the clusters with a silica layer using the Stöber sol–gel method;
Step 3: Deposition of an outer calcium hydroxide shell by reducing a calcium precursor;
Step 4: Decorated magnetic dental composite material with silver nanoparticles.
Each synthesis step was designed to be simple, reproducible, and environmentally sustainable, contributing to the development of a composite material with enhanced functionality suitable for dental restorative applications.
Figure 1.
TEM and SEM images illustrating the morphology of the initial magnetic precursors: (A) Fe3O4-OA nanoparticles coated with oleic acid; (B) size distribution histogram of Fe3O4 nanoparticles; (C) image of the magnetic ferrofluid prepared from Fe3O4-OA dispersed in toluene; (D) SEM image showing a general view of the hydrophilic magnetic clusters; (E) TEM detail of a hydrophilic magnetic cluster.
Figure 1.
TEM and SEM images illustrating the morphology of the initial magnetic precursors: (A) Fe3O4-OA nanoparticles coated with oleic acid; (B) size distribution histogram of Fe3O4 nanoparticles; (C) image of the magnetic ferrofluid prepared from Fe3O4-OA dispersed in toluene; (D) SEM image showing a general view of the hydrophilic magnetic clusters; (E) TEM detail of a hydrophilic magnetic cluster.
- 1.
Step 1—Synthesis of Hydrophilic Magnetic Clusters (MCs)
Among the recent strategies to improve the magnetic performance of magnetic nanoparticles (MNPs), the formation of magnetic clusters stands out due to its multiple advantages. This approach involves the self-assembly of hundreds of nanoparticles into compact, cohesive structures, known as magnetic clusters (MCs), which exhibit enhanced collective magnetic behavior.
The preparation of hydrophilic magnetic clusters (MCs) was carried out using a direct oil-in-water miniemulsion technique and is illustrated schematically in
Scheme 1 (step 1 of the reaction), [
19]. In the first step, two immiscible phases were mechanically mixed using a glass spatula: an aqueous phase (100 mL) containing the stabilizing surfactant sodium lauryl sulfate (SLS, 0.2 g) and an organic oily phase consisting of a ferrofluid (MF/toluene containing Fe
3O
4 nanoparticles stabilized with oleic acid, Ms = 445 G, ρ = 1.318 g/cm
3), corresponding to 0.5 g of magnetite (Fe
3O
4) nanoparticles. Emulsification of the two phases was achieved using an ultrasonic sonotrode (UP200S Hielscher) for 2 min at 50% amplitude in continuous mode, which generated fine droplets of the organic solvent (toluene) containing dispersed magnetic nanoparticles within the aqueous medium. SLS surfactant promoted micelle formation during the process, where the surfactant molecules self-organized with their hydrophilic functional groups exposed to the aqueous medium and their hydrophobic alkyl chains embedded in the organic droplets. This resulted in a stable miniemulsion, in which the toluene droplets associated and were coated with the surfactant, encapsulating the magnetic nanoparticles. The resulting colloidal solution was then heated for 1 h at 80 °C to evaporate the toluene from the micellar structures. The hydrophilic magnetic clusters thus obtained were magnetically separated from the reaction medium, washed three times by applying a water–methanol mixture in order to remove residual impurities, and finally re-dispersed as a stable aqueous colloidal solution of known concentration.
- 2.
Step 2—Synthesis of SiO2-covered functionalized magnetic nanomaterial (MCs-SiO2)
Although magnetic clusters (MCs) represent advanced magnetic structures with excellent magnetic properties, their chemical—and especially mechanical—stability is not high enough for practical use in dental materials. To address this limitation, a silica (SiO2) coating of controlled thickness was applied on their surface. This coating is chemically inert and resistant to the action of the various environments that may be experienced in the oral cavity while improving the mechanical robustness of the clusters and contributing to the overall stability of the resulting functionalized magnetic nanomaterial.
The silica shell was synthesized using the classical Stöber sol–gel method [
20], which is via hydrolysis and the subsequent condensation of tetraethyl orthosilicate (TEOS) in an alcoholic medium, with ammonia serving as a catalyst, and is presented schematically in
Scheme 1 (step 2 of the reaction). In our approach, the process was adapted to facilitate the deposition of silica directly onto the surface of the previously obtained magnetic clusters.
In our composite system, the SiO2 layer serves primarily to enhance the mechanical and chemical stability of the magnetic clusters, facilitating their uniform dispersion and integration within the dental resin matrix. Unlike crystalline silica, which is typically used for structural or thermal functions in prosthodontic investment materials, the amorphous SiO2 coating in this case plays a protective and stabilizing role, supporting the long-term performance of the composite under physiological conditions.
Specifically, 400 mL of an ethanol–water solution (ethanol–water volume ratio 4:1) was prepared in a Berzelius beaker. To this solution, 1.5 g of the silica precursor TEOS was added under continuous magnetic stirring at 500 rpm. Subsequently, 4.7 mL of the aqueous colloidal solution of magnetic clusters, corresponding to 1 g of wet sample, was introduced into the reaction mixture. While maintaining the same stirring conditions at room temperature, 8 mL of 25% aqueous ammonia solution was added dropwise to initiate hydrolysis and condensation. The reaction system was magnetically stirred at 500 rpm for 1 h under ambient conditions to ensure the uniform formation of the silica layer on the magnetic cluster surfaces. The silica-functionalized magnetic clusters were magnetically isolated from the reaction mixture at the end of the process. The resulting material was washed three times with 100 mL portions of deionized water to remove residual reactants, followed by re-dispersion in distilled water at specific concentrations for further use.
- 3.
Step 3—Synthesis of Ca(OH)2-covered functionalized magnetic nanomaterial (MCs-SiO2-Ca(OH)2)
A major inconvenience in integrating magnetic materials into aesthetic and restorative dental materials is their naturally dark colors. Magnetic nanoparticles typically exhibit a black color, which may visually disturb the appearance of the final functionalized magnetic nanomaterial in an inappropriate way, compromising its aesthetic acceptability. To address this limitation, an external coating able to mask the dark color and enhance the visual properties is essential. In this work, calcium hydroxide (Ca(OH)
2) was selected as an outer coating layer due to its dual function: it provides a significant improvement in the overall aesthetics of the final functionalized magnetic nanomaterial and contributes to pulpal desensitization by promoting local calcification and stimulating the development of secondary dentin. Additionally, its radio-opacity acts as an effective barrier to thermal and electrical conduction. The Ca(OH)
2 layer was deposited onto the MCs-SiO
2 composite surface through the direct reduction of a calcium-based precursor in an alkaline (NaOH) medium, as illustrated in
Scheme 1 (step 3 of the reaction) [
21].
To synthesize MCs-SiO2-Ca(OH)2, 94.5 g of calcium nitrate (Ca(NO3)2·4H2O) was initially solubilized in distilled water to obtain an 8.5 wt% solution. Subsequently, 1.2 mL of a colloidal suspension containing 1 g (wet mass) of MCs-SiO2 magnetic composites was introduced into the solution. An alkaline medium prepared with sodium hydroxide, prepared at 1.6% concentration and containing 16 g NaOH, was added dropwise at 1 mL/min under intense magnetic agitation (1000 rpm) at ambient temperature. Roughly 30 min into the addition, turbulence was observed in the mixture, accompanied by the appearance of a white solid of Ca(OH)2 began to form. After allowing the reaction to proceed for 3 h under ambient conditions, the resulting mixture was filtered, and the precipitate was rinsed three times with 100 mL portions of distilled water. The resulting solid was oven-dried at 60 °C for 1 h as the final step.
- 4.
Step 4—Decorated functionalized magnetic nanomaterial with silver nanoparticles
The integration of silver nanoparticles into the functionalized magnetic nanomaterial matrix plays a crucial role in enhancing its antimicrobial properties, effectively inhibiting biofilm formation and thereby extending the longevity of the dental restoration in the oral environment. Thus, silver nanoparticles (Ag
0) were deposited on the surface of the magnetic clusters functionalized with a bilayer of SiO
2 and Ca(OH)
2 via a chemical precipitation method. Silver nitrate (AgNO
3) was used as a silver precursor. The reduction of Ag
+ ions to metallic silver (Ag
0) is facilitated by the combined action of the alkaline environment provided by ammonia and the presence of ethanol, which acts as a mild reducing agent. This method enables the controlled in situ formation and uniform deposition of silver nanoparticles on the composite surface without the need for strong chemical reducers and is presented schematically in
Scheme 1 (step 4 of the reaction) [
22].
To functionalize the composite material with silver nanoparticles, 0.5 wt% of the dental composite was dispersed in a 5% ammonia–alcohol solution and sonicated for 30 min to obtain a homogeneous colloidal suspension. Subsequently, an alcoholic solution containing 7.5 wt% silver nitrate (AgNO3) was added dropwise under continuous magnetic stirring at 500 rpm. The reaction was allowed to proceed at room temperature for a duration of 3 h. At the end of the process, the silver-functionalized composite was separated from the reaction medium using a magnet, washed three times with a water–methanol mixture to remove residual reagents, followed by thermal drying at 60 °C in an oven.
In order to validate the potential of this composite material for dental restorative applications, a comprehensive point-by-point characterization was performed, aimed at evidencing each relevant property—morphological, structural, mechanical, magnetic, and biological—in direct correlation with the functional requirements of dental restoration.
Morphological characterization of the functionalized magnetic nanomaterial was performed using electron microscopy in both transmission and scanning transmission modes (TEM and STEM). The morphological evolution was monitored step by step throughout the synthesis process, enabling detailed observations at each stage in the construction of the final functionalized nanomaterial. In
Figure 1A, magnetite (Fe
3O
4) nanoparticles characterized by a mean size of ~7 nm (
Figure 1B) are shown, uniformly dispersed, and coated with a monolayer of oleic acid. This ferrofluid (
Figure 1C) served as the precursor source of magnetite nanoparticles for the subsequent synthesis steps. Due to its excellent colloidal stability, ensured by the individual coating of each nanoparticle with a protective oleic acid layer, the natural tendency of magnetic aggregation and/or agglomeration was effectively suppressed.
Figure 1D,E illustrate the successful formation of hydrophilic magnetic clusters, composed of densely packed nanoparticles aggregated into well-defined structures with a controlled shape and size, averaging around 100 nm. Due to the presence of an individual oleic acid layer on each nanoparticle, these clusters exhibit enhanced magnetic receptivity through collective effects as well as improved colloidal stability in aqueous media, making them ideal building blocks for further functionalization in a dental composite system.
Figure 2 displays electron microscopy images obtained using both scanning (SEM), which provides detailed information about the surface topography of the materials, and transmission (TEM), which reveals internal morphology and fine structural features at the nanoscale of the magnetic clusters at each stage of the functionalization process, highlighting the structural changes induced by successive surface modifications. In
Figure 2A, the hydrophilic magnetic clusters appear uniformly coated with a thin silica (SiO
2) shell, measured to be approximately 3–5 nm, exhibiting a smooth and continuous surface characteristic of amorphous silica structures. The deposition process does not induce any visible aggregation or agglomeration as each magnetic cluster remains individually encapsulated within a homogeneous silica layer.
This uniform coating significantly enhances the colloidal stability of the system and contributes to improved chemical and mechanical robustness of the resulting material, providing a solid foundation for further functionalization or dispersion in aqueous environments. In
Figure 2B, the deposition of a secondary coating layer based on calcium hydroxide [Ca(OH)
2] results in an increased thickness of the structurally amorphous layer surrounding the magnetic core in the range of 4–6 nm, confirming the contribution of the calcium-based layer.
The SEM image of the cluster assemblies appears relatively aggregated; however, this effect is attributed to the drying process during sample preparation on the measurement grid, which causes shrinkage and compaction of the sample rather than indicating true aggregation in dispersion. In
Figure 2C, particularly in the TEM image, the presence of colloidal silver (Ag) nanoparticles can be observed, with an average size of approximately 5–7 nm. These nanoparticles are relatively uniformly distributed within the outer layer, suggesting a controlled deposition that ensures their optimal spatial arrangement to achieve the desired antimicrobial effect.
Figure 3 presents the surface elemental distribution within the final dental composite material, as revealed by EDX elemental mapping. The purpose of this analysis was to generate detailed data on the presence and spatial distribution of key functional elements. The results demonstrated a uniform and continuous dispersion of silicon, calcium, and silver across the composite surface, confirming the successful and homogeneous integration of each functional layer into the final material.
To confirm the successful formation of the functionalized magnetic nanomaterial, their chemical composition was investigated using X-ray Photoelectron Spectroscopy (XPS). XPS measurements were carried out using a SPECS spectrometer equipped with a dual Al/Mg anode and a PHOIBOS 150 2D CCD hemispherical electron analyzer. The X-ray source employed was Al Kα radiation with an excitation energy of 1486.6 eV. The investigated samples, prepared as colloidal solutions, were dried on indium foil attached to a sample holder using carbon tape prior to introduction into the analysis chamber. Measurements were performed at room temperature under a vacuum of approximately 2 × 10−9 Torr. XPS data analysis was conducted using the CasaXPS software.
Figure 4 shows the high-resolution XPS spectra, representing the intensity as a function of binding energy (B.E.) for C1s, O1s, Si2p, S2p, and Fe2p, obtained from a representative sample of magnetic clusters stabilized with sodium lauryl sulfate (SLS) and coated with SiO
2.
The deconvolution of the XPS spectra reveals the chemical states of the detected elements, confirming the formation of clusters with SLS and SiO2 coatings. The C1s spectrum contains two components attributed to C–C/CH and C–O groups, originating from the oleic acid bound to the surface of the magnetic nanoparticles within the clusters. The O1s spectrum includes three components assigned to Fe–O, C–O/OSO3, and COO groups. The presence of the surfactant sodium lauryl sulfate used in the cluster formation is evidenced by the OSO3-related contribution in the O1s spectrum and by the S2p spectrum.
The silica coating is confirmed by the SiO2-related component in the O1s spectrum and the distinct signal observed in the Si2p spectrum. Due to the presence of the SiO2 layer, the intensity of the Fe2p spectrum is significantly reduced, preventing the identification of the components corresponding to the iron oxidation states.
Figure 5 shows XPS analysis performed at high resolution for C1s, O1s, Ca2p, and Si2p obtained from a representative sample of magnetic clusters stabilized with sodium lauryl sulfate (SLS) and SiO
2/Ca-bilayer-coated clusters. The Ca2p spectrum, along with the Ca–O and OH components in the O1s spectrum, confirms the presence of the calcium hydroxide coating on the clusters. Deconvolution of the C1s spectrum reveals three components attributed to C–C/CH, C–O, and CO
3 groups. The appearance of the CO
3-related component at 290 eV indicates the formation of a surface layer of CaCO
3. This C1s component decreases in intensity after argon ion sputtering, as shown in
Figure 6, supporting the conclusion that a thin layer of CaCO
3 forms only at the surface of the particles.
Magnetic characterization was performed using a vibrating sample magnetometer (VSM, Cryogenics Ltd.).
Figure 7 presents a comparative analysis of the magnetization curves corresponding to materials obtained at different stages of the preparation of the magnetic dental composites. Compared to the uncoated magnetic cores, a gradual decrease in the saturation magnetization was recorded after surface modification, as follows: Ms = 62 emu/g for hydrophilic magnetic clusters; Ms = 32 emu/g for clusters coated with a SiO
2 layer; and Ms = 14 emu/g for clusters functionalized with a bilayer composed of SiO
2 and Ca(OH)
2. Since the inorganic SiO
2 and Ca(OH)
2 layers are non-magnetic, the absolute value of the saturation magnetization is not very relevant in this context. Considering the expected application of this material in dental restorations, where it will be located on the tooth surface under the influence of an external magnetic field, the relevant parameter is the magnetic moment of the composite system, determined by the magnetic core, i.e., the hydrophilic magnetic clusters.
These clusters exhibit relatively high magnetization values compared to previously reported models, which makes the novel functionalized magnetic nanomaterial promising for various magnetic field-assisted dental applications.
Evaluating chemical stability is a critical factor in the evaluation of the functionalized magnetic nanomaterial for dental use, given their long-term exposure to the complex biological environment of the oral cavity, particularly the continuous pH fluctuations. To evaluate the material’s behavior under such conditions, its chemical stability was analyzed under different pH environments. Hydrodynamic diameters were obtained via dynamic light scattering (DLS) characterization of the functionalized magnetic nanomaterial in different solution media, providing valuable information on their colloidal stability and aggregation tendencies in aqueous media.
Figure 8 illustrates the evolution of hydrodynamic diameters for the magnetic composites throughout the synthesis process, as determined under varying pH conditions.
Figure 8 shows that the hydrodynamic diameters of hydrophilic magnetic clusters (MCs) and inorganic-coated composites (MCs-SiO
2 and MCs-SiO
2-Ca(OH)
2) are larger than their physical dimensions estimated from TEM measurements. This difference is normal because the hydrodynamic diameter also includes the effect of how the material surface interacts with water. In this case, the sulfonic groups on the surface of the hydrophilic clusters as well as both SiO
2 and Ca(OH)
2 layers exhibit hydrophilicity and interact with water through hydrogen bonding. These interactions explain the higher hydrodynamic diameter compared to the actual particle size determined by TEM.
For the investigated materials, a more pronounced increase in the hydrodynamic diameter was observed for magnetic clusters coated with a SiO
2 layer compared to simple magnetic clusters, functionalized with sulfonic groups, and those coated with Ca(OH)
2. This difference can be explained by the influence of the interfacial electric double layer generated at the boundary between the solid surface and the liquid medium. The SiO
2 surface is rich in silanol (-SiOH) groups, which can partially ionize in aqueous media, resulting in the formation of negatively charged surfaces. These charges attract counterions in solution, forming an extended electric double layer. This hydrated ionic layer increases the overall thickness around the particle, resulting in a larger measured hydrodynamic diameter [
23]. In contrast, sulfonic groups on the surface of the hydrophilic clusters are more compact and produce a less-extended double layer, while the Ca(OH)
2 coating—although hydrophilic—has a lower degree of ionization and tends to form a weaker and less-stable electric double layer due to its lower acidity and moderate solubility [
24]. The observed differences in hydrodynamic diameter are influenced not only by the surface chemistry of the particles but also by their electrostatic interactions in aqueous media, which can be explained by electric double-layer formation and classical colloidal stability theories [
25,
26].
However, when analyzing the final functionalized magnetic nanomaterial coated with both SiO2 and Ca(OH)2 layers, no significant changes in hydrodynamic diameter were observed across the tested pH values. This indicates that the composite maintains good stability regardless of the pH, which is particularly relevant given that dental materials operate in the oral environment, where pH can vary considerably, especially in saliva.
An essential property of materials used in dental restorative procedures is their ability to induce calcium and phosphate ion accumulation on the enamel surface. Zeta potential analysis offers an indirect method for evaluating the surface bioactivity of the material in aqueous solution. It is well-established that negatively charged surfaces favor the nucleation of apatite and facilitate local mineralization processes [
27,
28].
As shown in
Table 1, the magnetic clusters (MCs) exhibit a slightly negative zeta potential, which increases in absolute value as the surface is progressively coated with the two inorganic layers. This trend suggests an enhancement in the material’s bioactive potential. The consistently negative zeta potential values observed, especially at physiological pH (pH = 7), support the expectation that the functionalized magnetic nanomaterial may contribute to site-specific calcification and initiate the formation of reparative dentin.
Effective thermal insulation is essential for dental restorative materials to prevent thermal stress on surrounding tissues. Materials exhibiting elevated thermal conductivity can be problematic, particularly when placed close to the dental pulp as they can transmit temperature variations caused by hot or cold food, resulting in discomfort for the patient. Thermal conductivity is the measure of the ability of a material to conduct heat and is usually measured as the amount of heat transferred per unit time through a temperature gradient of 1 °C [
29]. In the present research, we propose a novel functionalized magnetic nanomaterial incorporating an outer layer of calcium hydroxide (Ca(OH)
2). The material has been commonly utilized for decades as a lining and underlining agent in restorative dentistry because of its therapeutic potential in pulp exposure cases and its ability to support the generation of dentin bridges [
30,
31]. The Ca(OH)
2 layer contributes to pulpal desensitization and stimulates the natural deposition of minerals and initiates the process of secondary dentin development. In addition, Ca(OH)
2 is radiopaque and provides effective thermal and electrical insulation, improving the overall performance of the composite in clinical applications [
32].
In order to evaluate the thermal insulation efficiency of the proposed functionalized magnetic nanomaterial, its thermal conductivity was determined and analyzed in relation to human dentin and several commonly used dental materials. The MCs-SiO
2–Ca(OH)
2 magnetic composites were characterized by a thermal conductivity of 0.527 W/m·K, nearly equivalent to that of dentinal tissue, 0.44 W/m·K [
33]. In comparison with standard dental restorative substances, our functionalized nanomaterial presented lower thermal conductivity values, detailed as follows: 0.77 W/m·K for composite resin, 1.20 W/m·K for enamel, 1.13 W/m·K for zinc phosphate cement, and 38.5 W/m·K for Au–Ag–Pd alloys [
34]. The data confirm that the developed magnetic nanomaterial has a thermal conductivity value similar to dentinal tissue and substantially below those recorded for conventional dental substances. This suggests that this material provides effective thermal insulation, making it a promising candidate for use in restorative dentistry.
Although electrical conductivity is not usually a primary consideration for dental materials, it can affect patient comfort in certain situations. For example, contact between a metal tool and a fresh metal filling can cause pain because saliva acts as an electrolyte, allowing electric current to flow between the metals, especially in teeth with deep restorations and limited dentin insulation. For this reason, in addition to thermal insulation, dental restorative materials must also have good electrical insulation. In this study, the MCs–SiO2–Ca(OH)2 functionalized magnetic nanomaterial exhibited an electrical resistivity of approximately 160 MΩ·cm, corresponding to a conductivity of 0.0065 S/cm. This places the material within the insulating range and supports its suitability for clinical use, offering both thermal and electrical insulation.
To highlight the potential of the magnetic dental composites for use in aesthetic restorative applications, colorimetric measurements were carried out on the functionalized magnetic nanomaterial obtained at various stages of the synthesis process. Color, defined as a perceptual quality determined by the spectral composition of incident light, was analyzed using the CIE Lab color space, a standardized model that quantifies color differences based on human visual perception [
35]. The CIE Lab* color system was developed to mathematically represent color differences based on human visual perception, using three parameters: L (lightness), a* (green-to-red axis), and b* (blue-to-yellow axis). The perceived color difference between two materials can be expressed using the ΔE value, which quantitatively reflects the distance between two colors in the CIE Lab* space (Equation (1)).
The spectral analysis covered the visible range of 360–830 nm, and the data obtained offer a relevant basis for evaluating the visual compatibility of the developed composites with natural dental tissues.
Table 2 provides an overview of the lightness parameter (L), the chromatic coordinates (a, b), and the resulting color deviation (ΔE), along with the individual components ΔL*, Δa*, and Δb*. These values were calculated by comparing each tested sample with a reference standard (commercial dental sample [
36]). The materials were evaluated at different stages of the magnetic dental composite preparation process, with the reference sample included for comparison.
From a colorimetric perspective, the parameter ΔL* represents variations in the lightness between samples. A positive ΔL* value suggests that the sample appears lighter than the reference standard, whereas a negative value implies a darker appearance. The chromatic components Δa* and Δb* correspond to shifts along the red–green and yellow–blue axes, respectively, within the CIE Lab color space. A positive Δa* indicates a redder hue relative to the reference, while a negative Δa* denotes a greener tone. In the same way, a positive Δb* reflects a shift toward yellow, and a negative Δb* points to a shift toward blue when compared to the reference sample.
Following the evaluation of colorimetric parameters, several observations can be made regarding the tested samples. The absolute value of the lightness difference (ΔL*) gradually decreases as the magnetic clusters with successive surface modifications, indicating an increase in brightness compared to the initial, uncoated form. This trend results in a final ΔL* value of just 5.3 units relative to the reference standard. A consistent reduction in the total color difference (ΔE) is also noted, which reaches a value of 11.76 units, suggesting enhanced color compatibility. The application of a dual coating layer composed of SiO2 and Ca(OH)2 visibly improves the optical characteristics of the material. Notably, the final composite exhibits a color profile that aligns well with the standard range accepted for dental restorative materials. It should also be noted that, in real-world dental applications, the magnetic composite is intended to be integrated into formulations together with other structural components, which are likely to further balance and refine the final aesthetic outcome.
The antimicrobial potential of the as-prepared functionalized magnetic nanomaterial was evaluated through standardized diffusion assays [
37] performed against a panel of clinically relevant bacterial strains—
E. coli (ATCC 25922),
E. faecalis (ATCC 29212),
P. aeruginosa (ATCC 27853), and
S. aureus (ATCC 25923)—through diffusion-based methods. These species were selected due to their known involvement in oral and systemic infections, as well as their differing cell wall structures (Gram-negative and Gram-positive), which allow for a broader assessment of antimicrobial effectiveness. The results of the inhibition zone measurements are presented in
Table 3 and provide a comparative overview of the bactericidal performance of the tested materials.
To investigate the antimicrobial properties, a biofilm formation assay was carried out against
Escherichia coli and
Pseudomonas aeruginosa of the functionalized magnetic nanomaterial containing MCs–SiO
2–Ca(OH)
2-Ag. The results indicated a mild bacteriostatic effect as uniform biofilm formation was observed following re-incubation, with visible bacterial growth present both on the material’s surface and in the surrounding medium (
Figure 9). Although the biofilm was not fully inhibited, these findings suggest that the tested material may contribute to reducing bacterial adhesion and proliferation, supporting its potential use as an antimicrobial component in dental restorative applications when combined with other strategies. Although full biofilm inhibition was not achieved, the observed bacteriostatic effect may be attributed to the presence of Ag nanoparticles. Ag NPs are known to exert antimicrobial effects through ROS generation and disruption of bacterial membrane integrity, mechanisms which can impair both planktonic and biofilm-embedded cells [
38,
39]. While such pathways were not directly investigated here, they support the rationale behind Ag incorporation.
Although cytotoxicity testing was not within the scope of the present study, the previous literature reports have shown that similar composites containing calcium hydroxide and magnetite nanoparticles exhibit low cytotoxicity and good biocompatibility in vitro [
40,
41,
42,
43]. Future studies will include dedicated cytotoxicity assays in collaboration with dental research groups to confirm the safety profile of the proposed material.
Direct shear bond strength testing was not performed in this study; instead, a related material developed in our previous work—based on Fe
3O
4 nanoparticles coated with a simple SiO
2 layer—was evaluated using optical microscopy in collaboration with dental professionals [
44]. The results demonstrated that the presence of iron-based MPs enabled magnetic field-assisted manipulation, leading to a significant reduction in the thickness of the adhesive layer. This thinning effect positively influenced the sealing capacity by lowering microleakage risk at the tooth–restoration interface. Building upon these encouraging results, we are confident that the current material, further enhanced by the use of clustered magnetic structures—a dual SiO
2–Ca(OH)
2 coating—and silver ion functionalization will exhibit at least comparable, if not improved, performance once optimized for clinical use. We look forward to validating these assumptions through dedicated bond strength analyses in collaboration with our dental partners.
Compared to conventional restorative materials such as glass ionomers and resin composites, the proposed magnetic composite introduces added value through magnetic responsiveness, antimicrobial effects via silver ions, and bioactivity through Ca2+ release. Its structure, based on Fe3O4 magnetic clusters, a SiO2 layer for mechanical reinforcement, and a Ca(OH)2 coating for remineralization and improved aesthetics offers a multifunctional platform. The ability to guide the material using an external magnetic field opens new application strategies, potentially reducing microfractures and secondary caries. While still in the prototype stage, this system provides a promising basis for the future development of advanced dental materials.
In the context of potential clinical translation, the safety of magnetic field-assisted application must be carefully considered. Based on our previous work [
44], where magnetic materials were preliminarily evaluated using both conventional and magnet-assisted placement methods, we anticipate that localized static magnetic fields up to 0.5 T, generated by permanent neodymium magnets, are sufficient to guide the material into confined spaces during application. Neodymium magnets are already employed in various medical and dental applications due to their ability to generate localized static magnetic fields. They are incorporated into devices used in chronic pain therapy, arthritis treatment, wound healing, insomnia, and headache management [
45], and have been reported to support tissue regeneration and bone formation through osteoblastic activation [
46,
47]. In the dental field, neodymium magnets have been used in orthodontic motion-generating systems, including molar distalization and palatal expansion appliances [
48,
49]. Furthermore, NASA has used neodymium magnets to preserve muscular tone in astronauts during spaceflight, highlighting their long-standing biocompatibility and functional integration in physiological regulation systems [
50,
51]. These examples support the rationale that magnetic guidance of restorative materials, when properly controlled, can be both effective and safe.